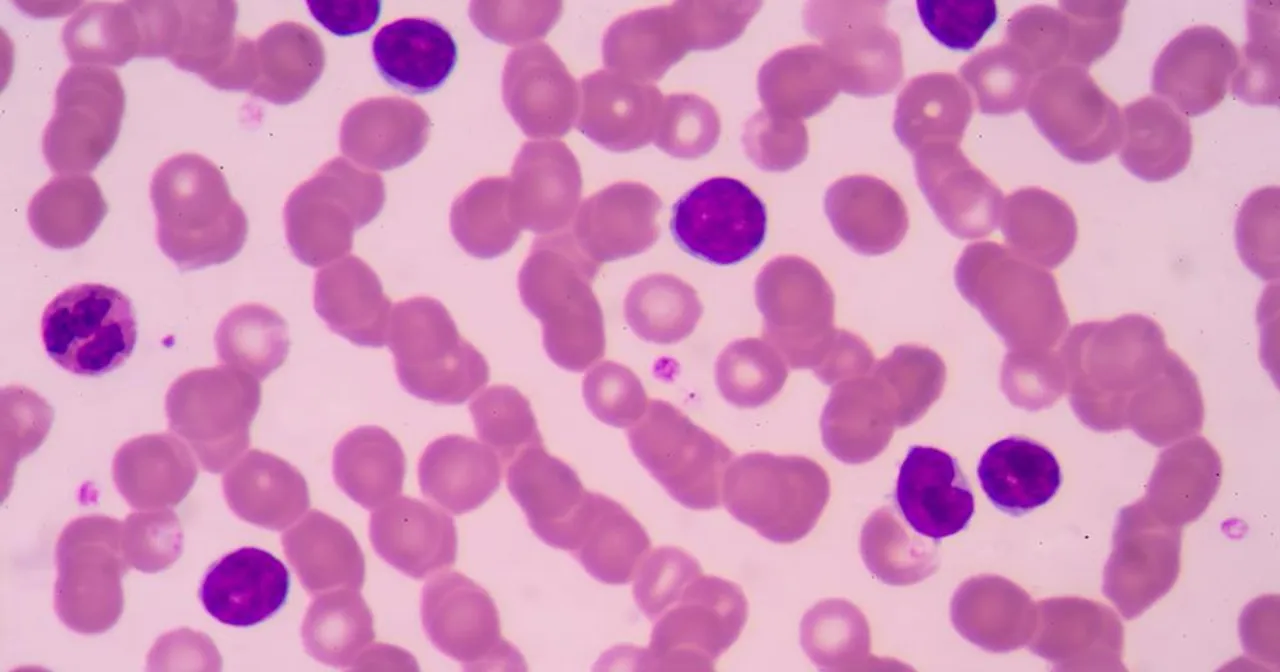
limfocyty pod mikroskopem

Otrzymałeś wyniki badań krwi, a w nich informację o podwyższonym poziomie limfocytów? To naturalne, że pojawia się niepokój i wiele pytań. W tym artykule, jako Marcel Lis, postaram się rozwiać Twoje obawy, wyjaśnić, co oznaczają te wyniki i wskazać, jakie kroki powinieneś podjąć, aby zadbać o swoje zdrowie.
Podwyższone limfocyty często wskazują na walkę organizmu z infekcją, ale zawsze wymagają konsultacji lekarskiej
- Limfocyty to kluczowe komórki odpornościowe, a ich podwyższony poziom (limfocytoza) świadczy o mobilizacji układu immunologicznego.
- Najczęstszą przyczyną limfocytozy są infekcje wirusowe, takie jak grypa, mononukleoza czy przeziębienie.
- Normy limfocytów różnią się znacząco w zależności od wieku (dzieci mają fizjologicznie wyższe wartości) oraz stanu fizjologicznego (np. ciąża).
- Poważniejsze przyczyny, takie jak choroby autoimmunologiczne czy nowotwory krwi, są rzadsze, ale wymagają dalszej diagnostyki.
- Zawsze należy skonsultować nieprawidłowe wyniki badań z lekarzem, który oceni kontekst kliniczny i zaleci ewentualne dalsze kroki.
Podwyższone limfocyty: co oznaczają Twoje wyniki badań?
Limfocyty to niezwykle ważne komórki w naszym organizmie. Stanowią one jeden z rodzajów białych krwinek, czyli leukocytów, i są kluczowym elementem naszego nabytego układu odpornościowego. Ich główna rola polega na rozpoznawaniu i zwalczaniu różnorodnych patogenów, takich jak wirusy, bakterie czy grzyby. Co więcej, limfocyty pełnią także funkcję "strażników" w walce z komórkami nowotworowymi, niszcząc je, zanim zdążą się rozwinąć. To prawdziwi bohaterowie naszej odporności!
Kiedy w wynikach badań krwi widzimy podwyższony poziom limfocytów, mówimy o zjawisku zwanym limfocytozą. To nic innego jak sygnał, że nasz układ odpornościowy jest w stanie mobilizacji. Zazwyczaj oznacza to, że organizm aktywnie walczy z jakimś zagrożeniem, próbując je wyeliminować. Moje doświadczenie pokazuje, że to często pierwszy wskaźnik toczącej się w ciele "bitwy".
Normy limfocytów: czy Twój wynik mieści się w zakresie?
Zrozumienie norm limfocytów jest kluczowe do prawidłowej interpretacji wyników. U dorosłych, procentowa norma limfocytów w stosunku do wszystkich leukocytów wynosi zazwyczaj od 20% do 45%. Co jednak ważniejsze, powinniśmy zwracać uwagę na ich bezwzględną liczbę, która u zdrowego dorosłego człowieka mieści się w przedziale od 1,5 do 4,5 tysiąca komórek na mikrolitr krwi (tys./µl). O limfocytozie u dorosłych mówimy, gdy liczba ta przekracza 4000, a niekiedy nawet 5000 komórek na mikrolitr. Pamiętaj, że laboratoria mogą mieć nieco inne zakresy referencyjne, dlatego zawsze warto porównać swój wynik z podanymi na wydruku normami.
U dzieci sytuacja wygląda nieco inaczej, ponieważ występuje u nich tak zwana fizjologiczna limfocytoza. Jest to całkowicie normalne zjawisko, szczególnie widoczne w wieku od około 3 miesięcy do 4-6 lat, i wiąże się z intensywnym rozwojem ich układu odpornościowego. W tym okresie limfocyty mogą stanowić nawet do 70% wszystkich białych krwinek! Przykładowo, dla dzieci w wieku 1-3 lat normy bezwzględne mogą wynosić 4-10,5 tys./µl, a dla 4-7 lat: 1,5-7 tys./µl. To pokazuje, jak bardzo różnią się normy w zależności od wieku.
Ciąża to kolejny stan fizjologiczny, który wpływa na poziom limfocytów. W pierwszym i drugim trymestrze ciąży ich poziom może fizjologicznie spadać, co jest naturalną adaptacją organizmu. Natomiast w trzecim trymestrze często obserwuje się ponowny wzrost. Zawsze podkreślam, że w przypadku kobiet w ciąży, interpretacja wyników powinna być szczególnie ostrożna i zawsze konsultowana z lekarzem prowadzącym.

Dlaczego limfocyty są podwyższone? Od infekcji po stres
Podwyższony poziom limfocytów może mieć wiele przyczyn, od tych najczęstszych i zazwyczaj niegroźnych, po te wymagające szczegółowej diagnostyki. W mojej praktyce najczęściej spotykam się z następującymi powodami:
- Infekcje wirusowe: To zdecydowanie najczęstsza przyczyna limfocytozy. Organizm reaguje wzrostem limfocytów na obecność wirusów, takich jak te odpowiedzialne za grypę, przeziębienie, mononukleozę zakaźną (wywołaną wirusem Epsteina-Barr), cytomegalię, odrę, świnkę, różyczkę czy ospę wietrzną. Wzrost ten jest zazwyczaj przejściowy i ustępuje po zwalczeniu infekcji.
- Infekcje bakteryjne: Chociaż w przypadku infekcji bakteryjnych częściej obserwujemy wzrost neutrofili, niektóre z nich, takie jak krztusiec, gruźlica, kiła czy choroba kociego pazura, również mogą prowadzić do podwyższenia poziomu limfocytów.
Nie tylko infekcje mogą wpływać na liczbę limfocytów. Choroby autoimmunologiczne, w których układ odpornościowy atakuje własne tkanki, takie jak reumatoidalne zapalenie stawów, toczeń czy choroba Hashimoto, często wiążą się z przewlekłym stanem zapalnym i mogą skutkować limfocytozą. Podobnie jest w przypadku przewlekłych stanów zapalnych, na przykład w przebiegu zapalenia jelit.
Warto pamiętać, że podwyższone limfocyty mogą być również efektem mniej oczywistych czynników. Reakcje na niektóre leki, nadczynność tarczycy, przewlekły stres, a nawet intensywny wysiłek fizyczny mogą tymczasowo podnieść ich poziom. Często obserwuję również limfocytozę w okresie rekonwalescencji, kiedy organizm wraca do pełni sił po przebytej chorobie. To pokazuje, jak wiele czynników może wpływać na ten parametr.
Poważne przyczyny limfocytozy: kiedy podwyższone limfocyty to sygnał alarmowy?
Choć w większości przypadków podwyższone limfocyty są wynikiem walki organizmu z infekcją, nie można ignorować sytuacji, gdy ich liczba jest znacząco podwyższona i utrzymuje się przez dłuższy czas. W takich okolicznościach limfocytoza może być sygnałem alarmowym wskazującym na poważniejsze schorzenia, w tym nowotwory układu krwiotwórczego. Mam tu na myśli takie choroby jak przewlekła białaczka limfocytowa (najczęstsza białaczka u dorosłych), ostra białaczka limfoblastyczna czy chłoniaki. W takich sytuacjach kluczowa jest szybka i dokładna diagnostyka.Jeśli podwyższonym limfocytom towarzyszą inne niepokojące objawy, zawsze zalecam pilną wizytę u lekarza. Mogą to być:
- Przewlekłe i niewyjaśnione zmęczenie, które nie ustępuje po odpoczynku.
- Nawracająca gorączka lub stan podgorączkowy bez wyraźnej przyczyny.
- Powiększone węzły chłonne, które są wyczuwalne i utrzymują się przez dłuższy czas.
- Niewyjaśniona utrata wagi, bez zmiany diety czy aktywności fizycznej.
- Nocne poty, które są tak obfite, że wymagają zmiany pościeli.
Morfologia krwi: na co jeszcze zwrócić uwagę poza limfocytami?
Interpretując wyniki morfologii krwi, rzadko skupiamy się tylko na jednym parametrze. W przypadku podwyższonych limfocytów, warto zwrócić uwagę na współwystępowanie podwyższonych monocytów. Często obserwujemy taki obraz w przypadku infekcji wirusowych, na przykład podczas mononukleozy zakaźnej. To połączenie może być dla lekarza cenną wskazówką diagnostyczną, pomagającą zawęzić krąg potencjalnych przyczyn.Kluczowe jest również zrozumienie różnicy między limfocytozą względną a bezwzględną. Limfocytoza względna oznacza, że odsetek limfocytów jest podwyższony, ale ich bezwzględna liczba może mieścić się w normie (np. gdy inne rodzaje białych krwinek są obniżone). Natomiast limfocytoza bezwzględna to sytuacja, w której faktyczna liczba limfocytów na mikrolitr krwi przekracza normę. Zawsze podkreślam, że to właśnie bezwzględna liczba limfocytów jest ważniejsza dla oceny stanu zdrowia i powinna być brana pod uwagę w pierwszej kolejności. Lekarz na pewno wyjaśni Ci tę różnicę.
Co robić, gdy masz podwyższone limfocyty? Praktyczny plan działania
Moja rada jest zawsze taka sama: zachowaj spokój, ale nie ignoruj sygnałów wysyłanych przez organizm. Jeśli podwyższone limfocyty pojawiły się po lekkiej infekcji, na przykład przeziębieniu, i nie towarzyszą im żadne niepokojące objawy, lekarz może zalecić obserwację i powtórzenie badań po pewnym czasie. Jednakże, jeśli wynik utrzymuje się dłużej, jest znacząco podwyższony lub towarzyszą mu wspomniane wcześniej objawy alarmowe, wizyta u lekarza jest absolutnie konieczna. Pamiętaj, że każdy wynik wykraczający poza normę wymaga profesjonalnej konsultacji.Pierwszym punktem kontaktu powinien być zawsze Twój lekarz rodzinny. To on, znając Twój wywiad medyczny i ogólny stan zdrowia, najlepiej oceni sytuację. W zależności od kontekstu klinicznego, lekarz rodzinny może zlecić dodatkowe badania lub, jeśli uzna to za konieczne, skierować Cię do specjalisty. W przypadku podejrzenia poważniejszych schorzeń układu krwiotwórczego, najczęściej będzie to hematolog specjalista od chorób krwi.
Aby znaleźć przyczynę podwyższonych limfocytów, lekarz może zlecić szereg dodatkowych badań. Mogą to być:
- Morfologia krwi z ręcznym rozmazem: Pozwala na dokładną ocenę wyglądu i proporcji poszczególnych rodzajów krwinek.
- Badania biochemiczne: Takie jak CRP (białko C-reaktywne) i OB (odczyn Biernackiego), które wskazują na obecność stanu zapalnego w organizmie.
- Badania wirusologiczne: W celu potwierdzenia lub wykluczenia konkretnych infekcji wirusowych.
- USG jamy brzusznej: Może pomóc w ocenie wielkości narządów, takich jak śledziona czy węzły chłonne.
- Biopsja szpiku kostnego: W uzasadnionych przypadkach, gdy istnieje podejrzenie chorób szpiku lub nowotworów krwi.
Chciałbym stanowczo rozwiać mity dotyczące "obniżania" limfocytów domowymi sposobami czy "cudownymi" suplementami. Podwyższone limfocyty to objaw, a nie choroba sama w sobie. Leczenie zawsze powinno być skierowane na przyczynę, która wywołała ten wzrost, a nie na sam objaw. Samodzielna interpretacja wyników i próby leczenia bez konsultacji z lekarzem mogą być nie tylko nieskuteczne, ale wręcz niebezpieczne. Zaufaj profesjonalistom, to oni posiadają wiedzę i narzędzia do postawienia trafnej diagnozy.
Podsumowanie: zachowaj spokój, ale nie ignoruj sygnałów organizmu
Podwyższony poziom limfocytów w wynikach badań krwi, choć może budzić niepokój, w większości przypadków jest sygnałem, że Twój układ odpornościowy aktywnie pracuje. Ważne jest, aby zachować spokój, ale jednocześnie nie ignorować tego sygnału. Kluczowe jest zrozumienie, że tylko profesjonalna diagnoza medyczna, oparta na kompleksowej ocenie Twojego stanu zdrowia, historii medycznej i dodatkowych badaniach, może wskazać prawdziwą przyczynę limfocytozy. Zdecydowanie odradzam samodzielne interpretowanie wyników i stawianie sobie diagnoz. Skonsultuj się z lekarzem to najlepsza droga do zrozumienia Twoich wyników i podjęcia ewentualnych dalszych działań.